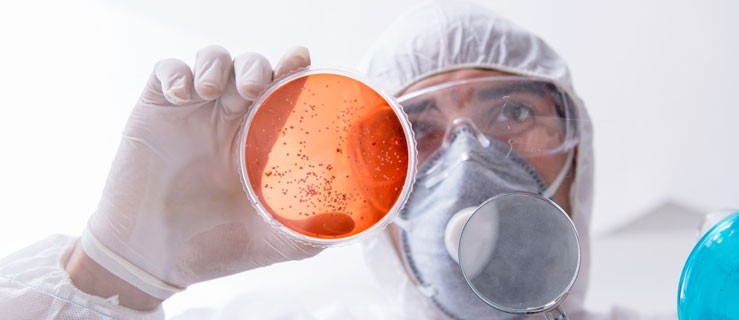

Wielkopolska. Coraz więcej zachorowań notuje Wojewódzka Stacja Sanitarno-Epidemiologiczna w Poznaniu. Zapadalność na grypę w naszym województwie jest najwyższa w kraju.
Sezon grypowy w pełni. 72,38 - tyle wynosiła zapadalność na grypę w Wielkopolsce na początku stycznia bieżącego roku i była jedną z najwyższych w kraju - podaje Wojewódzka Stacja Saniterno-Epidemiologiczna w Poznaniu.Na każde 100 tysięcy osób zarejestrowano w tym czasie ok. 72 nowe przypadki, to zachorowania na grypę.
Sezon wzmożonych zachorowań na grypę trwa od października do kwietnia następnego roku, Najwiecej ludzi choruje między styczniem a marcem.
Grypa to ostre wirusowe zakażenie górnych dróg oddechowych, wywoływane przez wirusy grypy. Przyczyną corocznych, sezonowych wzrostów zachorowań na grypę w okresie jesienno-zimowym są wirusy grypy typu A i B. Grypa przenosi się z osoby na osobę drogą kropelkową podczas kichania, kaszlu lub w wyniku bezpośredniego kontaktu ze świeżą wydzieliną z dróg oddechowych zakażonych osób.
Objawy grypy wystepują nagle. Sa to
- wysoka gorączka, dreszcze, bóle mięśni, bóle głowy, uczucia rozbicia i osłabienia, ogólnie złe samopoczucia;
- objawów ze strony układu oddechowego - suchy kaszel, ból gardła i katar
- u małych dzieci grypa moze objawiać się w inny spsób niż u dorosłych. Rodzice obserwują zmienione zachowanie dziecka, senność lub rozdrażnienie, brak apetytu, wymioty.
Jak uchronić się przed grypą?
Przestrzegając poniższych zasad:
- przestrzegaj zasad higieny oddychania – w czasie kaszlu i kichania zakrywaj nos i usta chusteczką jednorazową,
- jak najczęściej myj ręce wodą z mydłem,
- poza domem i w podróży zawsze miej przy sobie żel lub płyn do rąk albo zapas jednorazowych chusteczek nasyconych roztworem alkoholu, gdyż warunki podczas podróży rzadko zapewniają możliwości częstego mycia rąk,
- jeśli chusteczki jednorazowe lub żel właśnie ci się skończyły, kichaj i kaszl w zgięcie łokciowe – twoje dłonie nie zostaną skażone wirusem i nie przeniesiesz go na inne osoby,
- w miejscach publicznych, środkach transportu unikaj niepotrzebnego dotykania powierzchni i elementów ich wyposażenia,
- unikaj masowych zgromadzeń, bliskiego kontaktu „twarzą w twarz” z innymi ludźmi w transporcie publicznym - zwłaszcza podczas dłuższych podróży,
- zadbaj, aby również twoje dziecko przestrzegało powyższych zaleceń,
- przy wystąpieniu objawów takich jak gorączka, bóle głowy, bóle mięśniowo-stawowe, kaszel, ból gardła lub duszność zgłoś się do lekarza. W przypadku podejrzenia lub rozpoznania grypy nie idź do pracy, zostań w domu do czasu ustąpienia objawów.
Choroba zwykle ustępuje po 3-7 dniach, ale kaszel, zmęczenie i uczucie rozbicia mogą się utrzymywać do ok. 2 tyg. Lekarze apelują, by nie lekceważyć grypy. Powikłania moga byc groźne nawet dla życia!
Według ekspertów najlepszym sposobem zapobiegania grypie są szczepienia ochronne.